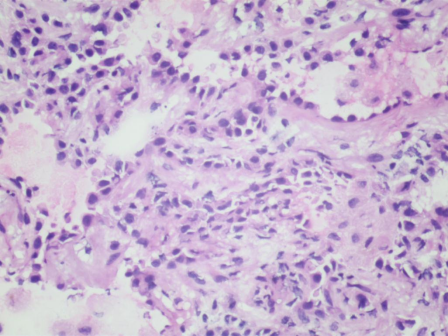

在医院,通常可以听到“某某科来了个急诊”“某某某需要做个急诊检查”,有很多人就会问“病理科有急诊吗?”。答案是“有”。有一种形式的病理报告,要求在30分钟内出具结果,就是术中冰冻。

什么是术中冰冻
术中冰冻,全称“术中快速冰冻病理诊断”,顾名思义,手术过程中将切取的新鲜组织在低温条件下快速冷却到一定硬度,然后进行切片、染色及诊断的方法,相当于术中的病理科急会诊,那它有多快呢?30分钟内就要给出病理结果,可能这30分钟对患者和术者来说,又何尝不是世界上最漫长的30分钟呢。


术中冰冻的作用
术中快速冰冻病理诊断能帮助手术医生在手术过程中快速得到病变区域的病理诊断,对于术中医生的决策至关重要,直接影响手术的进行和患者的后续治疗方案,根据病变的良恶性实施适合的手术方式,若冰冻结果是良性,则只需要切除病灶即可,若冰冻结果是倾向恶性,就需要扩大切除范围或调整手术方案。

哪些情况适合做术中冰冻
并不是所有手术都需要术中快速冰冻检查,它有明确的适用范围。
★需要确定病变性质(如肿瘤或非肿瘤、肿瘤良恶性等),以决定手术方案的标本。
★了解恶性肿瘤的扩散情况(如肿瘤是否浸润相邻组织、有无区域淋巴结转移等)。
★确定肿瘤是否切除干净(如乳腺、胃肠疾病手术中确定手术切缘肿瘤组织的残留情况)。
★辨认切除的组织(如甲状旁腺、输卵管、输精管及异位组织等)。
哪些情况不适合做术中冰冻
★疑为恶性淋巴瘤的病例。
★过小的标本(<0.2cm)。
★术前易于进行常规活检者。
★脂肪组织、骨组织和钙化组织。
★需要依据核分裂相计数判断良、恶性的软组织肿瘤。
★要根据肿瘤生物学行为特征而不能依据组织形态判断良、恶性的肿瘤。
★已知具有传染性的标本(如结核、病毒性肝炎、艾滋病等)。
术中冰冻的局限性
术中冰冻虽然及时快速,但有一定的局限性!首先,标本是在低温下快速冷冻切片,未经充分固定和处理,会导致组织过度收缩变形,组织中含有较多水份,制片过程中容易产生冰晶,从而影响观察;其次,因取材有限,可能选取的组织不具有较强的代表性;最后,时间紧迫等因素,导致冰冻诊断报告的准确性不如慢工出细活的常规报告。
目前国内外术中冰冻诊断的准确率在90%-95%之间,略低于常规石蜡病理诊断。这也是为什么术中冰冻诊断报告中经常会注明“具体结果待石蜡切片进一步诊断”。

保山市二院术中冰冻技术帮助手术医生找准方向,提高手术效果,确保患者的安全和健康。

供稿|病理科
扫一扫在手机打开当前页



